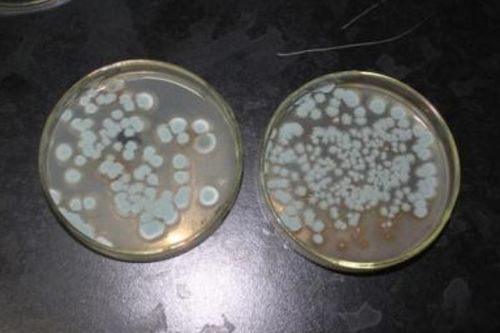
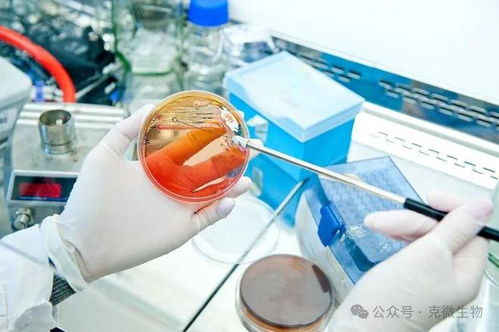

培养基制备的详细步骤
作者:佚名 来源:未知 时间:2024-11-17
培养基的制备步骤详解
培养基是微生物学、细胞生物学和生物技术等领域中不可或缺的基础材料,它为微生物或细胞的生长、繁殖提供了必要的营养物质和环境条件。正确地制备培养基是确保实验成功和结果准确性的重要环节。本文将从培养基的配制准备、称量、调配、调节pH值、过滤、分装、灭菌以及储存与使用等几个方面,全面介绍培养基的制备步骤。

一、配制准备
在配制培养基之前,需要进行一系列的准备工作,以确保培养基的纯净度和无菌状态。
1. 玻璃仪器的准备:
使用前,吸管、锥形瓶、毛细吸管、平皿等玻璃仪器需用肥皂水洗刷,并用清水冲洗干净,晾干备用。
平皿需包好或装在金属盒内,进行121℃高压蒸汽灭菌3分钟后烘干备用。
试管管口用棉花塞或硅氟塑料试管塞塞好,进行121℃高压蒸汽灭菌20分钟后烘干备用。
其他玻璃器皿按上述方法处理,并装在金属筒内进行160℃干热灭菌2小时备用。
2. 配制用水:
配制培养基通常使用纯化水,并需定期检查其微生物污染情况。
3. 准备其他材料和设备:
包括天平、磁力搅拌器、pH计、滤纸或纱布、灭菌锅等。
二、称量
根据培养基的配方,准确称量各成分。
1. 称量固体成分:
按照配方要求,将各固体成分(如琼脂、蔗糖、牛肉浸出粉、酵母浸出粉等)准确称量并放入烧杯中。
对于不是粉状的成分(如肉膏),可直接用烧杯称量。
2. 准备母液:
有些培养基配方中需要母液,母液一般按配方比例提前配制好,并在使用时按顺序加入。
三、调配
向烧杯中加入适量的水,进行搅拌溶解。
1. 溶解固体成分:
加入水后,用磁力搅拌器或手工搅拌,使固体成分完全溶解。
对于不易溶解的成分,可适当加热,但避免过度加热导致营养成分破坏。
2. 加入其他成分:
根据配方要求,加入葡萄糖、氯化钠等易溶成分,继续搅拌至完全溶解。
四、调节pH值
培养基溶解均匀并冷却至室温时,进行pH值调节。
1. 测定pH值:
使用pH计或pH试纸测定培养基的pH值。
2. 调节pH值:
根据配方要求的pH值范围,用预先配制好的无菌氢氧化钠溶液、碳酸钠溶液或盐酸溶液进行调节。
注意灭菌后的pH值可能会有所变化,一般高压灭菌前将pH值调高0.2左右。
五、过滤
过滤是去除培养基中杂质和微生物的重要步骤。
1. 选择过滤材料:
常用的过滤材料有滤纸、多层纱布等。
2. 进行过滤:
将配制好的培养基倒入过滤器中,进行过滤,确保培养基清澈透明,无杂质。
六、分装
将过滤后的培养基分装入适当的容器中。
1. 选择容器:
根据实验需求,选择试管、锥形瓶、平皿等容器。
2. 分装培养基:
将培养基小心倒入容器中,避免溅出和污染。
固体培养基需趁热分装,液体和半固体培养基可在灭菌前分装。
3. 封口:
用棉塞、硅胶塞等封好容器口,确保无菌状态。
七、灭菌
灭菌是确保培养基无菌的关键步骤。
1. 选择灭菌方法:
常用的灭菌方法有高压蒸汽灭菌、干热灭菌等。
高压蒸汽灭菌是最常用的方法,灭菌时间和压力根据培养基成分不同而定。
2. 高压蒸汽灭菌:
将分装好的培养基放入灭菌锅中,进行高压蒸汽灭菌。
普通培养基通常在121℃、103.42kPa下灭菌15分钟;含糖培养基在115℃、68.85kPa下灭菌30分钟。
灭菌过程中,应严格执行操作规程,确保灭菌效果。
八、储存与使用
灭菌后的培养基需妥善储存,并在使用前进行检查。
1. 储存条件:
严格按照生产厂家标明的储存条件保存。
开封后的培养基要密闭保存,实验室自制培养基需避光、干燥保存。
2. 使用前检查:
在使用前,检查培养基的pH值、色泽和均匀度等指标,确保符合要求。
如发现培养基有变色、浑浊、沉淀等异常情况,应立即丢弃,不得使用。
3. 使用注意事项:
倾注平板培养基时,需倾注于灭菌平皿中,形成至少3mm厚度。
斜面培养基需趁热斜放在玻璃棒上,待其凝固后使用。
液体培养基分装后进行灭菌处理,使用前需摇匀。
常见培养基的制备示例
以下是一些常见培养基的制备示例,供读者参考。
1. 硫乙醇酸盐流体培养基:
配方:胰酪胨15.0g、酵母浸出粉5.0g、葡萄糖/无水葡萄糖5.5g/5.0g、氯化钠2.5g、L-胱氨酸0.5g、新配制的0.1%刃天青溶液1.0mL、硫乙醇酸钠0.5g(或硫乙醇酸0.3mL)、琼脂0.75g、水1000mL。
制备步骤:除葡萄糖和刃天青溶液外,取上述成分混合,微温溶解,调节pH为弱碱性,煮沸,滤清,加入葡萄糖和刃天青溶液,摇匀,调节pH,使灭菌后在25℃的pH值为7.1±0.2。分装至适宜的容器中,灭菌后使用。
2. 胰酪大豆胨液体培养基:
配方:胰酪胨17.0g、氯化钠5.0g、大豆木瓜蛋白酶水解物3.0g、磷酸氢二钾2.5g、葡萄糖/无水葡萄糖2.5g/2.3g、水1000mL。
制备步骤:除葡萄糖外,取上述成分混合,微温溶解,滤过,调节pH使灭菌后在25℃的pH值为7.3±0.2,加入葡萄糖,分装,灭菌后使用。
3. 0.5%葡萄糖肉汤培养基:
配方:胨10.0g、氯化钠5.0g、牛肉浸出粉3.0g、葡萄糖5.0g、水1000mL。
制备步骤:除葡萄糖外,取上述成分混合,微温溶解,调节pH为弱碱性,煮沸,加入葡萄糖溶解后,摇匀,滤清,调节pH使灭菌后在25℃的pH值为7.2±0.2,分装,灭菌后使用。
4. 马铃薯葡萄糖琼脂培养基(PDA):
配方:马铃薯(去皮)200g、琼脂14.0g、葡萄糖20.0g、水1000mL。
制备步骤:取马铃薯,切成小块,加水1000mL,煮沸20~30分钟,用6~8层纱布过滤,取滤液补水至1000mL,调节pH使灭菌后在25℃的pH值为5.6±0.2,加入琼脂,加热溶化后,再加入葡萄糖,摇匀,分装,灭菌后使用。
结语
培养基的制备是一项复杂而精细的工作,涉及多个步骤和环节。通过本文的介绍,读者可以全面了解培养基的制备步骤和注意事项,为微生物和细胞培养提供良好的生长环境。同时,读者也可以根据不同实验需求,选择合适的培养基配方和制备方法,以确保实验的准确性和成功性。
- 上一篇: 轻松掌握:如何开启并设置QQ声音提醒
- 下一篇: 轻松掌握:如何设置电脑开机启动项
































